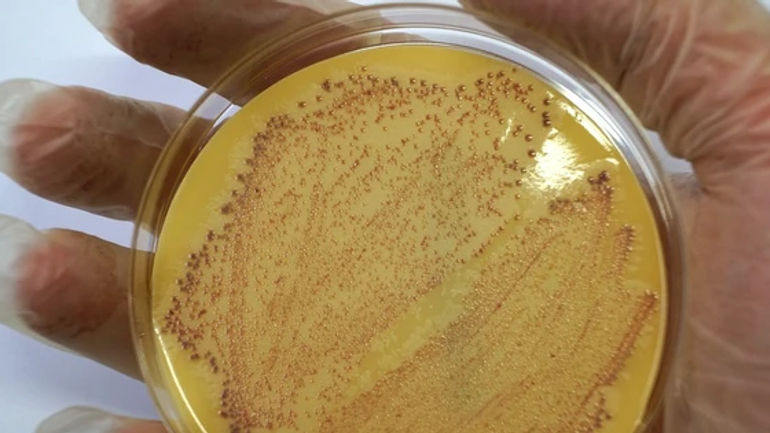
Hành trình đau lòng của cô gái 29 tuổi trước siêu vi khuẩn 'đục lỗ phổi'

Hành trình đau lòng của cô gái 29 tuổi trước siêu vi khuẩn 'đục lỗ phổi'
Một câu chuyện đau lòng về cô gái 29 tuổi với siêu vi khuẩn gây nên bi kịch
Hành trình bất ngờ
Câu chuyện về cô gái 29 tuổi Ashley Timbery từ Úc đã gây xôn xao và đau lòng khi cô tử vong chỉ sau 10 ngày nhiễm phải siêu vi khuẩn đục lỗ phổi. Trong sự bất ngờ và đau buồn, mọi người không khỏi bàng hoàng trước sự tàn khốc của căn bệnh này.
Cô gái trẻ vốn khỏe mạnh bỗng dưng gục ngã bên đường, mở ra một hành trình đầy bi kịch và hối tiếc.
Siêu vi khuẩn 'đục lỗ phổi'
Ashley được chẩn đoán nhiễm Staphylococcus vàng kháng methicillin, hay còn gọi là siêu vi khuẩn MRSA, một loại vi khuẩn tàn phá cơ thể và gây ra viêm phổi nghiêm trọng. Sự lây lan nhanh chóng của siêu vi khuẩn này đã khiến cô phải đối mặt với cái chết.
Cô gái 29 tuổi vốn khỏe mạnh tử vong 10 ngày sau khi nhiễm siêu vi khuẩn đục lỗ phổi - Ảnh 1.
Cảnh báo và phòng tránh
Theo Dịch vụ Y tế Quốc gia Anh (NHS), MRSA có thể gây ra những biến chứng nghiêm trọng nếu không được điều trị kịp thời. Việc phòng tránh và giữ gìn vệ sinh cá nhân là điều cực kỳ quan trọng để ngăn chặn sự lây lan của vi khuẩn này.
Nếu bạn hoặc người thân của bạn gặp các triệu chứng nghi ngờ, hãy đến bệnh viện để được kiểm tra và điều trị kịp thời.
Cô gái 29 tuổi vốn khỏe mạnh tử vong 10 ngày sau khi nhiễm siêu vi khuẩn đục lỗ phổi - Ảnh 2.













